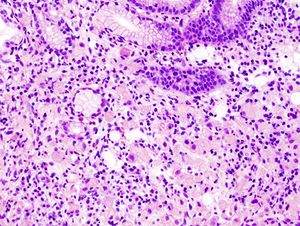

سرطان المعدة
سرطان المعدة | |
---|---|
![]() | |
A suspicious stomach ulcer that was diagnosed as cancer on biopsy and resected. Surgical specimen. | |
التبويب والمصادر الخارجية | |
التخصص | علم الأورام, طب الجهاز الهضمي |
ICD-10 | C16. |
ICD-9-CM | 151 |
OMIM | 137215 |
DiseasesDB | 12445 |
eMedicine | med/845 |
Patient UK | فشل عرض الخاصية P1461: لم يتم العثور على الخاصية P1461. سرطان المعدة |
MeSH | D013274 |
سرطان المعدة، هو أحد أنواع السرطان التي تصيب المعدة ويمكن أن تنتشر منها إلى أي عضو من أعضاء الجسم مثل المرئ، الرئتين، الكبد. ويتسبب سرطان المعدة في وفاة حوالي 800.000 شخص حول العالم سنويا.[1]
ويعد سرطان المعدة ثاني أكثر السرطانات شيوعاً في العالم بعد سرطان الرئة. وهو شائع خصوصاً في اليابان والصين . ربما نتيجة لبعض العوامل التغذية ، وعدد الإصابات بهذا الورم السرطاني لبطانة المعدة هو في تزايد مستمر في العالم الغربي.
يميل سرطان المعدة الى الإنتشار بسرعة ، لذا يتركز العلاج غالبا على تقليل سرعة إستفحال المرض وإنتشاره بدلاً من معالجته وشفائه. وفي اليابان ، حيث تُجرى عمليات تقصي واسعة ، يتم تشخيص المرض في مرحلة مبكرة ويشفى حوالي 90% من المصابين.
وهو ثاني السرطانات المميتة في المملكة المتحدة إذ يسبب نحو سبعة آلاف وفاة سنوياً فيها، ويصاب به نحو 24000شخص في الولايات المتحدة الأمريكية سنوياً. ويؤلف هذا المرض تحدياً كبيراً للأطباء والباحثين، إذ أنه على الرغم من التطور الذي تحقق في طرائق الكشف المبكر والعلاج، فإن نسب الشفاء منه ما تزال منخفضة.
تشكل السرطانات الغدية adenocarcinomas نحو 90% من مجمل السرطانات المعدية، في حين تشكل اللمفومات lymphomas، و السَرَطاوي (الكارسينوئيد) carcinoid، و الأورام السدوية (أورام اللحمة) stromal tumors الـ 10% الباقية.
بدأ سرطان المعدة في الولايات المتحدة الأمريكية ومنذ الثلاثينات من القرن العشرين، في التناقص، فانخفض معدل الإصابة به من 40 حالة لكل 100ألف نسمة عام 1930 إلى عشر حالات لكل 100ألف نسمة عام 1990، غير أنه، ما زال واحداً من السرطانات العشرة الأولى التي تسبب الوفاة في تلك البلاد، عند الذكور والإناث على حد سواء.
يشاهد سرطان المعدة غالباً في الأعمار المتقدمة، وتختلف نسب الإصابة به بحسب الجنس، إذ تبلغ الإصابة عند الذكور ضعف إصابة الإناث. كما تختلف نسب الإصابة والوفيات بسببه حسب التوضع الجغرافي، فتشاهد نسب عالية منها في بلدان معينة مثل تشيلي وكوستاريكا وهنغاريا والبرتغال وسنغافورة ورومانيا (الشكل ـ1). وتحدث أعلى نسب الوفيات بسببه في اليابان (50% عند الذكور، و40% عند الإناث). ويُعتقد أن السبب الرئيس لارتفاع نسب الإصابة في تلك البلاد عائد إلى مسرطنات بيئية environmental carcinogens، مصدرها الغذاء غالباً.
كانت سرطانات منطقة الغار الأكثر مشاهدة، إلا أن هذا بدأ يتغير منذ الثمانينيات في القرن العشرين إذ بدأت سرطانات الأقسام القريبة من المعدة (الفؤاد والجسم) بالتزايد على حساب سرطانات الغار. ينشأ سرطان المعدة عادة في بطانة المعدة ، لكنه قد ينتشر بسرعة الى مواضع أخرى في الجسم ، وتزيد أعمار معظم المصابين بهذا النوع من السرطان على 50 عاماً ، وتبلغ نسبة إصابة الرجال به ضعف إصابة النساء. [2]
الأعراض

غالبا ما تكون الأعراض مبهمة وغير واضحة وهو ما قد يؤدي إلي التشخيص المتأخر للمرض ويتسبب في انتشاره ويجعل توقع الشفاء ضعيف. يوصف البعض أنها كشكاوى قرحة المعدة ولكنها تختلف أن المريض يعاني منها فجأة ولأول مرة بعد سن الأربعين بعكس الحال مع القرحة .
إن أعراض سرطان المعدة هي غالباً غير نوعية non-specific وتلتبس في أحيان كثيرة مع أعراض الآفات المعدية غير السرطانية، وخاصة القرحة المعدية السليمة benign gastric ulcer.
يحدث الألم البطني الشرسوفي في 70% من مرضى المراحل المبكرة لسرطانات المعدة، وغالباً ما يكون مستمرا ًوغير منتشر، ولا يتحسن بتناول الأطعمة. وبسبب استجابة الألم للعلاج بمضادات الحموضة عند بعض مرضى المراحل المبكرة، فإن ذلك قد يؤخر مراجعة المريض للطبيب ظناً منه أن الآفة سليمة المنشأ. ويشكو أكثر من 70% من المرضى من أعراض مبهمة تستمر لمدة ستة أشهر وسطياً قبل مراجعة الطبيب.
يشاهد القَهم anorexia والغثيان nausea ونقص الوزن في نسبة من مرضى المراحل المبكرة من سرطانات المعدة قد تبلغ نحو 50% (الشكل ـ2)، وتزداد مع تقدم مرحلة المرض.
من الأعراض الأخرى المشاهدة: عسرة البلع dysphagia في أورام المعدة القريبة من الفؤاد وتشاهد عند 20% من المرضى، والنزف الهضمي العلوي upper GI bleeding عند 5% من المرضى، وانثقاب المعدة gastric perforation عند 1% منهم. ولا تشاهد غالباً علامات سريرية صريحة في المرحلة المبكرة. ويمكن جس كتلة واضحة في البطن، في المراحل المتأخرة من المرض، كما يمكن ملاحظة ضخامة كبديةhepatomegaly أو ضخامات عقد لمفية فوق الترقوة مما يشير إلى احتمال وجود انتقالات ورمية metastasis وتطور مرحلة الورم.
الأعراض المبكرة
الأعراض المتأخرة
- ألم في الجزء العلوي من البطن
- قئ
- إسهال أو إمساك
- خسارة للوزن وضعف عام
- نزيف يؤدي إلى قيء للدم أو ظهور دم في البراز أو يؤدي إلى الفقر الدم
الأسباب
ـ الآفات قبل السرطانية في المعدة premalignant gastric lesions: تزداد خطورة تشكل سرطانات المعدة عند وجود سلائل (بوليبات) polyps داخل المعدة. وهناك أنواع من السلائل في المعدة، الأول منها هو سلائل فرط التنسُّج hyperplastic polyps، وتصادف عند 0.5 إلى 1% من السكان، وتؤلف نحو 80% من سلائل المعدة، وهي لا تملك قدرة التحول السرطاني. أما النوع الثاني من السلائل فهو السلائل الغدية adenomatous polyps، وهي قادرة على التحول الخبيث. وتُقدَّر نسبة التسرطن فيها بنحو 10 إلى 20% خاصة إذا زاد حجم السَليلة عن 2سم أو كانت هناك سلائل متعددة.
ـ التهابات المعدة gastritis: تكثر نسبة مشاهدة التهابات المعدة الضمورية المزمنةchronic atrophic gastritis وسرطانات المعدة مع تقدم العمر. ويترافق غالباً التهاب المعدة المزمن مع تغيرات خلوية مهمة بكونها قبل سرطانية، يذكر منها الحؤول المعوي intestinal metaplasia وثَدَن (خلل تنسج) الغشاء المخاطي mucosal dysplasia. وإن أكثر أنواع التهابات المعدة المزمنة ترافقاً مع احتمال التسرطن هي تلك المترافقة مع فقر الدم الوبيل pernicious anemia
ـ أخماج الملوية البوابية helicobacter pylori infections: تزايد الاهتمام مؤخراً بالدور الذي يمكن أن تقوم به الأخماج الناجمة عن الملوية البوابية في تطور سرطان المعدة. وقد لوحظ ارتفاع نسبة الأخماج بسبب هذا الجرثوم، في أماكن تزايد نسبة سرطان المعدة، ويعتقد أنها تسبب التهاباً مزمناً في النسيج المخاطي في المعدة، وخاصة إذا كان التعرض لها مبكراً منذ مراحل الطفولة، مما يجعل مخاطية المعدة أكثر تأهباً للتغيرات البيئية المسرطنة. تترافق الأخماج المزمنة بهذا الجرثوم بزيادة نسبة سرطانات المعدة المتوضعة في جسم المعدة وغارها وليس بسرطانات الفؤاد. كما تترافق الإصابة بهذا الجرثوم مع زيادة نمط خاص من اللمفومات المعدية يدعى MALT lymphomas، ويمكن لهذه الأورام أن تتراجع وتشفى أحياناً بالقضاء على هذا الجرثوم.
ـ عمليات جراحية سابقة في المعدة: يتزايد حدوث سرطان المعدة في القسم المتبقي بعد عمليات قطع المعدة. وقد تبين أن احتمال التسرطن يبدأ بالتزايد بعد نحو 25سنة من إجراء العمل الجراحي. وتقدر نسبة ذلك بنحو 3 إلى 10%. ومن الأسباب المؤهبة لذلك زيادة القلس الصفراوي bile reflux للجيب المعدي، ونقص حموضة المعدة، وزيادة حدوث التهاب المعدة المزمن الضموري.
ـ عوامل وراثية: توجد أدلة على وجود توارث أُسرِي لسرطانات المعدة، ومن أكثر العائلات شهرة في هذا الصدد عائلة بونابرت فسرطان المعدة كان السبب بوفاة نابليون بونابرت وأبيه وجده وثلاث من أخواته. وهنالك أسباب وراثية لدى نحو 10% من مرضى سرطان المعدة. وقد أثبتت دراسات حديثة أهمية الجين (المورث) E-cadherin/CDH1 الموجود على الصبغي 16، والذي ينتمي البروتين الناتج عنه إلى عائلة من جزيئات مهمة في تحقيق اتصال الخلايا، ولها دور مهم في المحافظة على التمايز الخلوي والتكوين الطبيعي للأنسجة الظِهارية، وقد وجدت طفرات في هذا الجين تسبب خللاً في الالتصاق الخلوي مما يؤهب للتكاثر الخلوي الشاذ. وعُثر على عائلات ظهر فيها سرطان المعدة نتيجة طفرة في الجين. وعموماً، فإن هنالك احتمالاً كبيراً لتطور سرطان المعدة في الأفراد الممتلكين للطفرة في عمر مبكر يقدر وسطياً بنحو 38سنة. وتُدرج المراجع العلمية تسعة جينات شائعة أخرى، وثمانية جينات أقل شيوعاً أو نادرة، مرتبطة بسرطانات المعدة. ومن جهة أخرى، فقد وُجد ارتباط بين حدوث سرطان المعدة والزمرة الدموية A.
ـ عوامل بيئية وغذائية: يعتقد أن لبعض الأغذية دوراً في إحداث سرطان المعدة، منها الأغذية الفقيرة بالحليب والبروتينات الحيوانية والفيتامينات، والغنية بالنشويات، وكذلك الأغذية الغنية بملح الطعام والمخللة pickled والأسماك المدخَّنة smoked fish التي تُستهلك بكثرة في بعض البلدان كاليابان والبلاد الاسكاندنافية. ويُعتقد أن العامل المسرطن في الأغذية المدخَّنة هو الهدروكربونات المتعددة الحلقات polycyclic hydrocarbons. وقد زاد الاهتمام مؤخراً بدور الأمينات الآزوتية nitrosamines الموجودة في الأغذية الغنية بالبروتينات والمواد الحافظة للغذاء food preservatives، وهي مسرطنة لمخاطية المعدة في حيوانات التجارب.
وهنالك عوامل أخرى قد يكون لها أدوار مسرطنة، منها التدخين، وزيادة استهلاك الكحول، وارتفاع نسبة الزنك والرصاص في مياه الشرب.
وتأكد من جهة أخرى، دور الفواكه والخضار في الوقاية من الإصابة بسرطان المعدة، ويعود ذلك لكون معظمها غني بالفيتامين C الذي يُعد من مضادات الأكسدة antioxidants المهمة، والتي تأكد دورها في الوقاية من السرطان.
الاستقصاءات
ـ الاستقصاءات المخبرية: تجرى الفحوص المخبرية المنوالية مثل فحص الخضاب والصيغة التي يمكن أن تكشف وجود فقر دم عند المريض anemia غالباً ما تكون على نمط فقر دم بعوز الحديد. كما تجرى اختبارات وظائف الكبد التي قد تكون مضطربة في حال وجود نقائل ورمية للكبد. يمكن كشف وجود الدم الخفي في البراز عند بعض مرضى سرطان المعدة.
يرتفع مستوى الواسم الورمي المسمى المستضد الجنيني الورمي(CEA) carcinoembryonic antigen في الدم عند 30% من مرضى المراحل المتأخرة بسرطان المعدة، وهو اختبار غير وصفي في مرضى السرطانات الباكر.
ـ الاستقصاءات الشعاعية radiography: لمدة طويلة كانت الصور الظليلة باللقمة الباريتية barium meal تعد الوسيلة الرئيسة لتشخيص سرطان المعدة، وقد أصبحت أكثر دقة عندما أشركت المادة الظليلة مع الهواء (التباين المضاعف) double contrast في استخدامها، مما ساعد الشعاعيين على دراسة مخاطية المعدة دراسة أدق وأوضح. ومع تطور التنظير الهضمي العلوي endoscopy بدأت الصور الظليلة باللقمة الباريتية تفقد دورها استقصاءاً تشخيصياً رئيساً.
يستخدم التصوير الطبقي المحوري CT-SCAN (الصورة ـ1) والتصوير بالأمواج فوق الصوتية ultrasound و الرنين المغنطيسي MRI scan لتشخيص النقائل وتحديد مرحلة الورم.
ـ التنطير الهضمي والخزعة: مع التطور الكبير في مجال صناعة المناظير الضوئية الليفية المرنة flexible fiberoptic endoscopes، صار من السهل إجراء فحص كامل ودقيق لمخاطية المعدة، ومشاهدة التغيرات المرضية، ومنها سرطان المعدة، مباشرة، وكذلك أخذ خزعات متعددة منها من أجل التشخيص النسيجي. ويجب أخذ 4 إلى 6 خزعات من أي آفة مشبوهة في المعدة لرفع دقة التشخيص.
يساعد التنظير الهضمي أيضاً على تحديد مكان الآفة في المعدة، ويمكن باستخدام التصوير بالأمواج فوق الصوتية خلال التنظير endoscopic ultrasound دراسة مدى ارتشاح الورم في جدار المعدة، ومن ثم التفريق بين سرطانات المعدة الباكرة والمتقدمة بدقة تصل إلى نحو 80%.
ـ تنظير البطن: يفيد تنظير البطن الاستقصائي diagnostic laparoscopy، كجزء من تقييم مرحلة الورم، في كشف النقائل الورمية الصغيرة في الصفاق peritoneum والكبد والتي يصعب كشفها بالوسائل الشعاعية الأخرى خاصة التصوير الطبقي. وبذلك يمكن تحديد مرحلة الورم بدقة أكبر، وتحديد الخطة العلاجية وقابلية الورم للعلاج الجراحي الشافي curative.
تاريخ المرض

مراحل المرض
التحكم في المرض
الجراحة
في حال عدم وجود نقائل ورمية بعيدة distant tumor spread، تُعد الجراحة حجر الأساس في العلاج الذي يهدف إلى الشفاء. ويعتمد المبدأ الجراحي على إجراء قطع جزئي أو تام للمعدة متضمناً الورم مع هامش من النسيج المعدي السليم حوله (نحو 6سم) لضمان الحصول على هامش خالٍ من الخلايا الورمية بالفحص المجهري.
يُجرى القطع الجزئي partial gastrectomy في حالة الأورام المتوضعة بالقسم البعيد من المعدة (أورام الغار antral tumors)، والقطع التام total gastrectomy في حالة الأورام المتوضعة في الجسم والفؤاد. تُعاد استمرارية الأنبوب الهضمي بعد القطع بمفاغرة anastomosis الأمعاء الدقيقة مع الجزء المتبقي من المعدة في حال القطع الجزئي، أو المريء في حال القطع التام. ويجب أن تستأصل العقد اللمفية المحيطة بالمعدة كجزء أساسي من العلاج الجراحي.
الاستئصال الموضّع بالتنظير endoscopic local excision
تطورت هذه الوسيلة في اليابان حيث ترتفع نسبة الكشف المبكر لسرطانات المعدة، ويعود ذلك إلى انتشار برامج المسح السكاني population screening. وهي تعتمد على استئصال الأورام الصغيرة السطحية بالتنظير، إما باستخدام حلقات خاصة loops تستأصل الأورام مع المخاطية تحتها، وإما باستخدام أشعة الليزر laser. وقد أظهرت بعض الدراسات نتائج مشجعة ومعدل بقيا survival rate وصل إلى 98% بعد ثلاث سنوات من العلاج.
ـ العلاج المتمم: بالرغم من استخدام العلاج الجراحي، فإن معدل النكس recurrence يبلغ نحو 80%، ولذا فقد ازداد الاهتمام بتطوير نظم (بروتوكولات) علاجية متممة adjuvant treatment تتبع العلاج الجراحي بهدف تحسين نتائج المعالجة ورفع نسبة البقيا، ومن أهمها:
العلاج الكيميائي chemotherapy
لم تظهر كل الدراسات الخاصة بدور العلاج الكيمياوي بعد الجراحة في سرطانات المعدة نتائج مشجعة وبالتالي لا يعد هذا العلاج ناجحاً في الوقت الحاضر. ويحتمل أن تتغير هذه الصورة في المستقبل مع ظهور نتائج الدراسات الحديثة التي تبحث نتائج المشاركة الدوائية بين العديد من الأدوية الكيمياوية، بدلاً من استخدام دواء واحد، كما كان في السابق. وقد أظهرت الدراسات التي استخدمت المشاركة بين الـ 5- فلورويوراسيل 5-flurouracil، والدوكسوروبيسين doxorubicin، والمايتومايسين mitomycin C C في حالات سرطان المعدة المتقدم استجابة جزئية تقدر بنحو 33%.
العلاج الإشعاعي radiotherapy
عُدَّ سرطان المعدة لمدة طويلة معنِّداً على العلاج الشعاعي radio resistant، لكن المشاهدات السريرية أظهرت أن تطبيق العلاج الشعاعي على سرطانات المعدة المتقدمة المتوضعة بمنطقة الفؤاد والمترافقة مع عسرة بلع شديدة، أدت إلى إنقاص حجم الورم ثم إلى تحسن ملحوظ بالأعراض السريرية. ومن ثم بدأ البحث في دور الأشعة في السرطانات المتقدمة، وفي محاولة تصغير حجم الورم وجعله أكثر قابلية للجراحة. وبوجه عام، لا يترافق العلاج الشعاعي بسرطان المعدة مع زيادة في معدلات البقيا.
العلاج الملطف
عندما تثبت الاستقصاءات السريرية أن سرطان المعدة أصبح في مراحل متقدمة، وأن العلاج الجراحي الشافي curative غير مجد، يمكن اللجوء إلى عدد من العلاجات التلطيفية palliative treatment التي ترمي إلى تحسين نمط الحياة عند المرضى quality of life من دون أن يكون لها أثر في تحسين معدلات البقيا.
من هذه الوسائل، العلاجات غير الجراحية مثل استخدام أشعة الليزر عبر التنظير الهضمي لتخثير النسيج الورمي المسبب لانسدادات أعلى المعدة، ثم تحسين أعراض عسرة البلع المرافقة. ويمكن استخدام الجراحة في بعض الحالات الخاصة كوسيلة ملطفة عندما تسمح حالة المريض بذلك، منها، مثلاً، إجراء مفاغرة بين المعدة وعروة معوية في الصائم jejunum لاجتياز انسداد في مخرج المعدة بسبب ورم كبير يسد منطقة الغار.
Multimodality therapy
المسح السكاني population screening
من المعروف أن العلاج الجراحي لسرطانات المعدة المكتشفة في وقت مبكر تترافق مع معدلات بقيا تفوق الـ 90%. ومن هذا المنطلق طورت بعض البلدان التي تزداد في سكانها سرطانات المعدة، وخاصة اليابان والتشيلي وفنزويلا، برامج دقيقة لإجراء مسح دوري للسكان غير العرضيين non-symptomatic بغية كشف سرطان المعدة في مراحل مبكرة.
تختلف الوسائل المتبعة لإجراء ذلك من بلد لآخر، ففي اليابان، مثلاً، يجري التصوير الظليل باللقمة الباريتية لنحو خمسة ملايين مواطن ياباني كل عام، وذلك باستخدام وحدات شعاعية متنقلة mobile screening units. وبعد انقضاء 25 سنة على بدء البرنامج، تناقصت نسبة الوفيات الناجمة عن سرطانات المعدة من 50 إلى 33% من مجمل الوفيات السرطانية عند الذكور، ومن 40 إلى 28% عند الإناث. كما تحسنت معدلات البقيا لأكثر من 50% بعد خمس سنوات من العلاج.
أما في البلدان التي لاترتفع إصابة سكانها بسرطان المعدة، فإن المسح يجرى على المجموعات السكانية العالية الخطورة أمثال مرضى السَلائل (البوليبات) المَعدية، والتهابات المعدة الضمورية atrophic gastritis، أو المرضى الذين وجدت عندهم حالات ثَدَنdysplasia في خزعات أخذت من المعدة عند تقييمهم لأسباب أخرى كالقرحات المعدية السليمة. ويستخدم التنظير الهضمي عادة وسيلة لإجراء الفحص في تلك البلدان.
وبوجه عام يجب أن يجري التنظير على أي مريض تجاوز سن الأربعين ويشكو من أعراض هضمية معدية غير معللة....[3]
علم الأوبئة

المصادر
- ^ "Cancer (Fact sheet N°297)". World Health Organization. 2009. Retrieved 2009-05-11.
{{cite web}}
: Unknown parameter|month=
ignored (help) - ^ برامج سوفت
- ^ سـرطان المعدة, الموسوعة العربية
- ^ "WHO Disease and injury country estimates". World Health Organization. 2009. Retrieved Nov. 11, 2009.
{{cite web}}
: Check date values in:|accessdate=
(help)
وصلات خارجية
- National Cancer Institute Gastric cancer treatment guidelines
- GeneReview/NIH/UW entry on Hereditary Diffuse Gastric Cancer
- No Stomach For Cancer | Be Strong Hearted is a source of information and support for Hereditary Diffuse Gastric Cancer and carriers of the CDH1 gene mutation and their families/friends.
- "Stomach Cancer. In: Iodine Deficiency: studies by dr. Sebastiano Venturi (Italy)". Retrieved 2008-05-15.